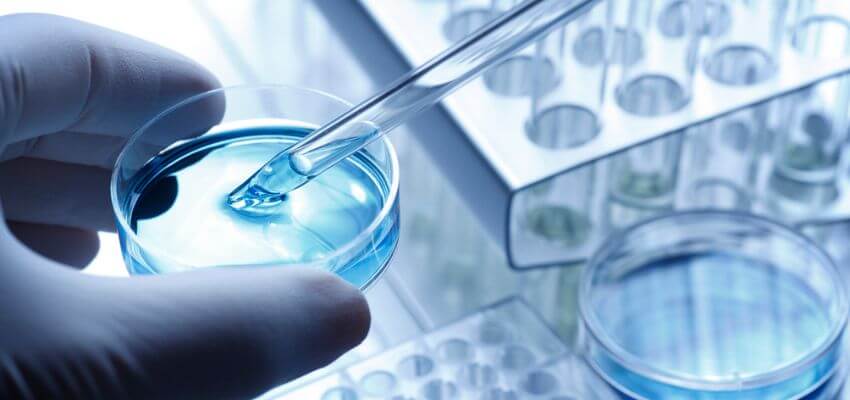
Scientist taking a sample out of a petri dish

Celebrating E7130: pushing the limits of complex drug synthesis
Drug discovery has reached another significant milestone with the large-scale synthesis of E7130 – an anticancer drug candidate its creators say is more complex than any other nonproteinaceous therapy prepared by total synthesis on the market, or undergoing clinical trials. Here, we detail the ‘outlandish’ story behind selecting halichondrin B as a starting point, together with the ‘gruelling’ synthesis routes and breakthrough refinements that enabled researchers to meet the unprecedented challenge of producing the drug.
In 2010, the FDA approved eribulin, recognised at the time as one of the most synthetically complex drugs to reach the market. Now, the liposarcoma drug’s creators – the Japan-based company, Eisai - are back with E7130, a related compound which was even tougher to produce. Recent papers have detailed the significant synthesis and scale-up innovations developed by Eisai and the Harvard University-based Kishi group in facilitating first-in-human clinical trials for patients with advanced solid tumours.
It is rare for drug candidates to justify such a lengthy process as the 92 synthesis steps needed to produce E7130 - either in terms of medical benefits or financial viability. However, it is very encouraging to see that, when such a molecule does emerge, chemists are up to the task of making it. E7130 is based on a structurally complex natural product called halichondrin B, isolated from various marine sponges. Halichondrin B shows remarkable anti-cancer activities against cell line and rodent models, and was expected to be developed as a therapeutic until the limited supply of natural sources prevented this.
In 1992, Kishi and colleagues reached a significant milestone in achieving the first total synthesis of halichondrin B. Writing recently in the journal Organic Letters, the Kishi group stated that “While the notion that halichondrin B could serve as a structurally simplified starting point still seemed outlandish enough from a chemistry and business standpoint”, an extensive anticancer drug research programme focusing on halichondrins was started nevertheless - with the Kishi team spearheading advancements in synthesis pathways, and Eisai taking charge of medicinal and process chemistry.
Together, their efforts culminated in the creation of E7130, a profoundly complex halichondrin class drug candidate with a molecular weight of 1066, and featuring a 52 carbon backbone - of which 31 are chiral centres. The Kishi group claims that: “To the best of our knowledge, the chemical structure of E7130 is more complex than that of any other nonproteinaceous drug prepared by total synthesis that is either on the market or currently undergoing clinical trials.”

As structural complexity increases, supplying a drug substance by total synthesis becomes exponentially more difficult due to the need for high overall efficiency, scalability, cost-effectiveness, product purity, and adherence to GMP regulations. For these reasons, the Kishi group regard the development of E7130 as an “unprecedented challenge in synthetic organic chemistry”.
E7130 itself is a novel, potent inhibitor of microtubule dynamics that functions with a distinct mechanism from other microtubule-targeting chemotherapies such as paclitaxel, and it also exerts anticancer activity by affecting the tumor microenvironment.
The first-generation synthesis used a modified version of Kishi’s original total synthesis of halichondrin B to produce a 1.6 mg batch of the drug substance for testing. This 109-step process included a gruelling 47-step linear sequence, but suffered from low yields in the final stages - making the route unsuitable for scale-up. The second-generation route fixed some of these issues, but also required some non-trivial HPLC work to remove a number of impurities.
The major breakthrough came with the third-generation route, in which the site of coupling of the two large fragments of the molecule was changed using a reaction featuring a novel Zr/Ni mediated ketone coupling that resulted in “marked improvements in the overall efficiency of synthesis”. In Organic Letters, Kishi group scientists stated that “one reason for this improvement was that the C40 and C44 stereocenters were already constructed in left half; therefore, the final deprotection and cyclization steps were significantly simplified, and the cumbersome sequential cyclization process could be avoided. In other words, the formation of various byproducts such as stereoisomers was minimized and HPLC purification was no longer needed.”
With this route, large-scale synthesis was accomplished only 18 months after the completion of the first milligram-scale synthesis. The Kishi group concludes: “we provide here evidence that contemporary organic synthesis can pave the way for drug discovery and development even for extremely complex natural products such halichondrins”.
LGC Standards – for all you need in research chemicals and reference materials
LGC Standards’ TRC brand has more than 40 years’ experience working through some of the most complex synthetic pathways to deliver you high quality research chemicals. Our world-leading chemists engineer specific solutions for customers, and we have a uniquely large range – featuring APIs, impurities, metabolites, building blocks, SILS and many novel bioactive molecules for research into areas including cancer, infectious diseases, and neuroscience. Need a custom molecule? Our synthetic chemists are up to the challenge! Enquire today.
Our Mikromol range of pharmaceutical reference materials meanwhile includes a wide selection of APIs, impurities and excipients, manufactured to the highest quality (ISO 17034 / 17025 accredited), and commonly used in method validation and drug product testing.
Distributed by LGC in Europe and Africa, the ATCC Biobank is the global leader in in vitro models - providing the world’s largest collection of cell lines, numerous advanced models, and microbiology tools.
|
Get more from LGC Standards